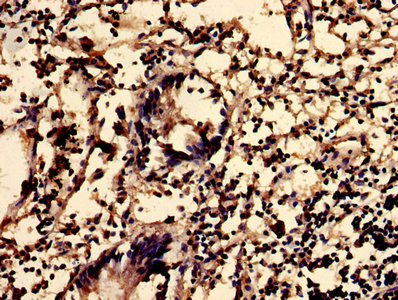

Western Blot Positive WB detected in: Rat liver tissue All lanes: SGMS2 antibody at 3microg/ml Secondary Goat polyclonal to rabbit IgG at 1/50000 dilution Predicted band size: 43 kDa Observed band size: 43 kDa
SGMS2 Antibody
CSB-PA854159LA01HU
ApplicationsImmunoFluorescence, Western Blot, ELISA, ImmunoHistoChemistry
Product group Antibodies
ReactivityHuman, Rat
TargetSGMS2
Overview
- SupplierCusabio
- Product NameSGMS2 Antibody
- Delivery Days Customer20
- ApplicationsImmunoFluorescence, Western Blot, ELISA, ImmunoHistoChemistry
- CertificationResearch Use Only
- ClonalityPolyclonal
- ConjugateUnconjugated
- Gene ID166929
- Target nameSGMS2
- Target descriptionsphingomyelin synthase 2
- Target synonymsCDL, SMS2, phosphatidylcholine:ceramide cholinephosphotransferase 2, SM synthase
- HostRabbit
- IsotypeIgG
- Protein IDQ8NHU3
- Protein NamePhosphatidylcholine:ceramide cholinephosphotransferase 2
- Scientific DescriptionSphingomyelin synthases synthesize the sphingolipid, sphingomyelin, through transfer of the phosphatidyl head group, phosphatidylcholine, on to the primary hydroxyl of ceramide. The reaction is bidirectional depending on the respective levels of the sphingolipid and ceramide. Plasma membrane SMS2 can also convert phosphatidylethanolamine (PE) to ceramide phosphatidylethanolamine (CPE). Major form in liver. Required for cell growth in certain cell types. Regulator of cell surface levels of ceramide, an important mediator of signal transduction and apoptosis. Regulation of sphingomyelin (SM) levels at the cell surface affects insulin sensitivity.
- ReactivityHuman, Rat
- Storage Instruction-20°C or -80°C
- UNSPSC41116161